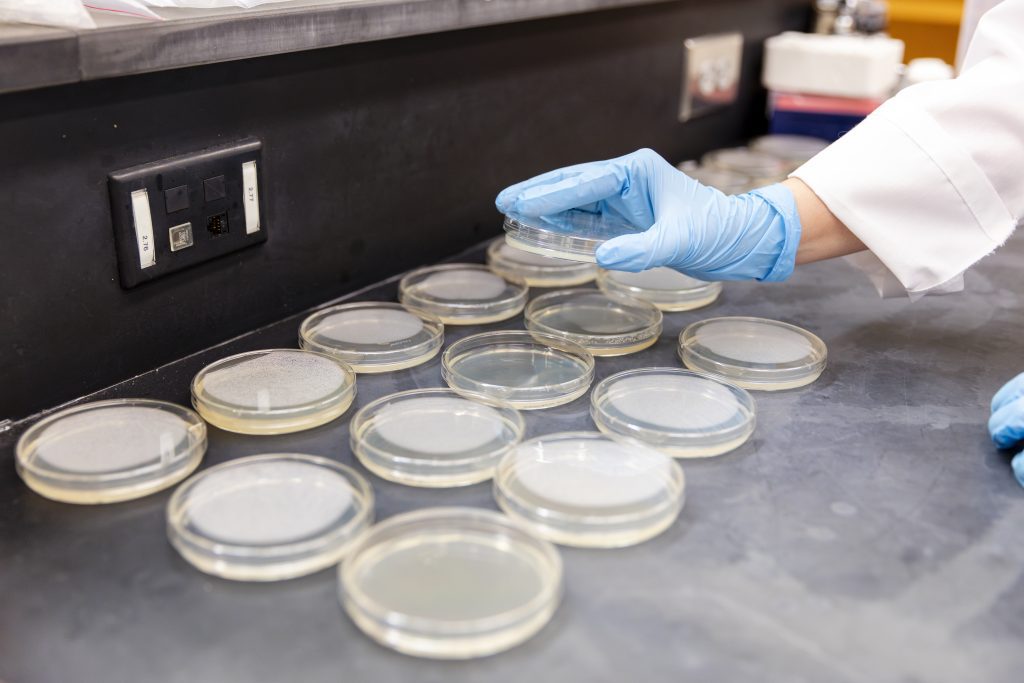

Bachelor of Science (BS), Natural Science
Your Degree
We practice the discovery of truth through the scientific method of data analysis while producing learners who are dedicated to a serving attitude as they emerge as leaders in the field of natural science.
Learning Outcomes
The Science building houses chemistry, biology and research labs, faculty offices and classrooms. A greenhouse is located adjacent to the science building.
Your Career
The College of Science and Mathematics ensures through its curricula and course offerings that students in all majors demonstrate an understanding of the continuing role of science and mathematics in human progress.
A faith-based natural science program
Examining the Christian worldview offers an abundance of benefits regardless of one’s major and career aspirations. Whether you are studying biochemistry, English, education, or business, diving deeply into worldviews will affect your life in all aspects, from guiding you to better understand your own spiritual perspective to shaping how you approach important conversations with those around you. Taking the time in college to study the Christian worldview will leave a lasting impact that reaches beyond just a credential on a resume.
Graduate opportunities
CSU offers several advanced degree programs in related fields, including a Master of Science in biology, which allows you to further specialize your knowledge and research skills. These graduate programs provide a pathway to careers in advanced research and specialized industries, giving you the credentials needed to pursue leadership positions in related scientific fields.
Natural Science Courses
As an Natural Science major, you’ll take courses like:
- Organic Chemistry
- Abstract Algebra
- General Physics
- Microbiology
- Zoology
- Genetics
Natural Science Career
Graduates are equipped for a variety of career paths.
- Biological Technicians
- Environmental Economists
- Environmental Restoration Planners
- Geological Research
- Service Management
- Mathematical Research
- Park Naturalists
Interested in this Program?
Request more information